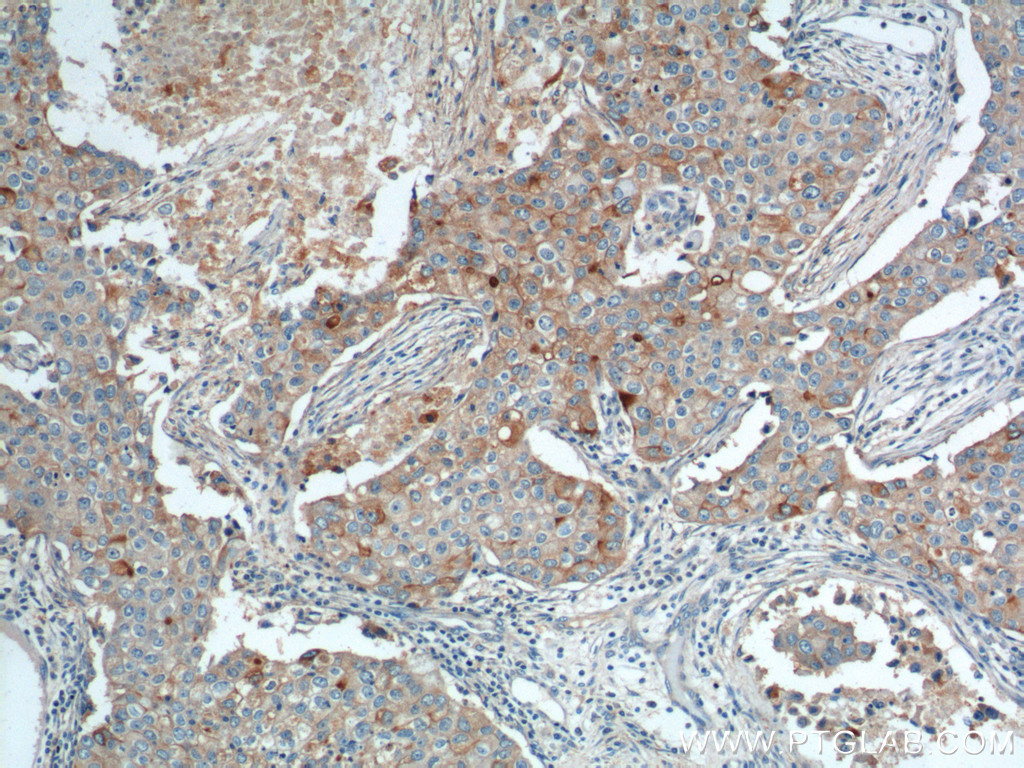

验证数据展示
经过测试的应用
| Positive WB detected in | A375 cells, MCF-7 cells, HeLa cells, RAW 264.7 cells |
| Positive IHC detected in | human lung cancer tissue, human breast cancer tissue, human colon cancer tissue, human lung squamous cell carcinoma tissue Note: suggested antigen retrieval with TE buffer pH 9.0; (*) Alternatively, antigen retrieval may be performed with citrate buffer pH 6.0 |
| Positive FC (Intra) detected in | HeLa cells |
推荐稀释比
| 应用 | 推荐稀释比 |
|---|---|
| Western Blot (WB) | WB : 1:1000-1:6000 |
| Immunohistochemistry (IHC) | IHC : 1:50-1:1000 |
| Flow Cytometry (FC) (INTRA) | FC (INTRA) : 0.40 ug per 10^6 cells in a 100 µl suspension |
| It is recommended that this reagent should be titrated in each testing system to obtain optimal results. | |
| Sample-dependent, Check data in validation data gallery. | |
产品信息
10309-1-AP targets GPRC5A,RAI3 in WB, IHC, IF, FC (Intra), ELISA applications and shows reactivity with human, mouse samples.
| 经测试应用 | WB, IHC, FC (Intra), ELISA Application Description |
| 文献引用应用 | WB, IHC, IF |
| 经测试反应性 | human, mouse |
| 文献引用反应性 | human, goat |
| 免疫原 |
CatNo: Ag0311 Product name: Recombinant human GPRC5A,RAI3 protein Source: e coli.-derived, PGEX-4T Tag: GST Domain: 106-330 aa of BC003665 Sequence: SICFSCLLAHAVSLTKLVRGRKPLSLLVILGLAVGFSLVQDVIAIEYIVLTMNRTNVNVFSELSAPRRNEDFVLLLTYVLFLMALTFLMSSFTFCGSFTGWKRHGAHIYLTMLLSIAIWVAWITLLMLPDFDRRWDDTILSSALAANGWVFLLAYVSPEFWLLTKQRNPMDYPVEDAFCKPQLVKKSYGVENRAYSQEEITQGFEETGDTLYAPYSTHFQLQNQP 种属同源性预测 |
| 宿主/亚型 | Rabbit / IgG |
| 抗体类别 | Polyclonal |
| 产品类型 | Antibody |
| 全称 | G protein-coupled receptor, family C, group 5, member A |
| 别名 | GPRC5A, GPCR5A, G-protein coupled receptor family C group 5 member A, PEIG-1, Phorbol ester induced gene 1 |
| 计算分子量 | 40 kDa |
| 观测分子量 | 40-45 kDa |
| GenBank蛋白编号 | BC003665 |
| 基因名称 | GPRC5A |
| Gene ID (NCBI) | 9052 |
| RRID | AB_2877732 |
| 偶联类型 | Unconjugated |
| 形式 | Liquid |
| 纯化方式 | Antigen affinity purification |
| UNIPROT ID | Q8NFJ5 |
| 储存缓冲液 | PBS with 0.02% sodium azide and 50% glycerol, pH 7.3. |
| 储存条件 | Store at -20°C. Stable for one year after shipment. Aliquoting is unnecessary for -20oC storage. |
背景介绍
GPRC5A, also named as GPCR5A, RAI3 and RAIG1, belongs to the G-protein coupled receptor 3 family. It is an orphan G-protein coupled receptor (GPCR) that has been associated with malignancy and may play a role in the proliferation of breast cancer cells. GPRC5A is a potential molecular target for treatment of breast cancers. It is suppressed in some human lung carcinoma cells. (PMID:15788639, 20563252, 19552806 )
实验方案
| Product Specific Protocols | |
|---|---|
| FC protocol for GPRC5A,RAI3 antibody 10309-1-AP | Download protocol |
| IHC protocol for GPRC5A,RAI3 antibody 10309-1-AP | Download protocol |
| WB protocol for GPRC5A,RAI3 antibody 10309-1-AP | Download protocol |
| Standard Protocols | |
|---|---|
| Click here to view our Standard Protocols |
发表文章
| Species | Application | Title |
|---|---|---|
Cell Prolif Spatially multicellular variability of intervertebral disc degeneration by comparative single-cell analysis | ||
Sci Total Environ GPRC5A reduction contributes to pollutant benzo[a]pyrene injury via aggravating murine fibrosis, leading to poor prognosis of IIP patients.
| ||
Biol Open Quantitative proteomic profiling of tumor-associated vascular endothelial cells in colorectal cancer. | ||
Oncol Lett Clinical significance of reduced GPRC5A expression in surgically resected non-small cell lung cancer. | ||
Exp Lung Res GPRC5a suppresses the proliferation of non-small cell lung cancer under wild type p53 background. | ||
Mol Med Rep Lung cancer suppressor gene GPRC5A mediates p53 activity in non‑small cell lung cancer cells in vitro. |